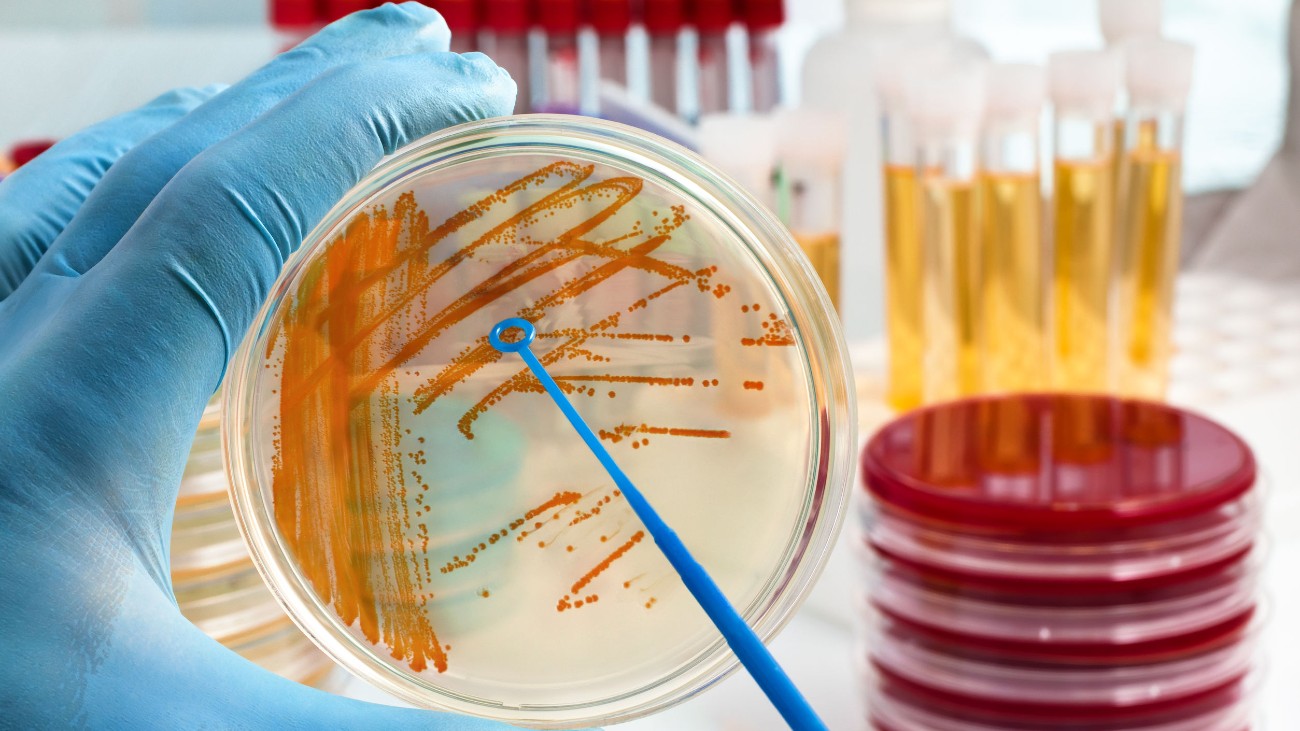

Ben je geïnteresseerd in de wereld van wetenschap & technologie en wil je hier graag meer over lezen? Word dan lid van KIJK!
Om te begrijpen hoe bacteriën onze gezondheid beïnvloeden, hebben wetenschappers voor het eerst een menselijk microbioom nagemaakt.
Het gehele arsenaal aan darmbacteriën – het zogeheten microbioom – speelt niet alleen een rol bij onze stoelgang en afweer. Steeds meer onderzoeken linken deze kleine wezens aan onze mentale gezondheid. Om die invloed, en andere effecten van darmbacteriën op de gezondheid, uit te zoeken, probeerden wetenschappers van de Amerikaanse Stanford-universiteit een menselijk microbioom na te maken. In het lab. En dat is het team nog gelukt ook.
Lees ook:

In onze darmen leven zo’n 30 biljoen micro-organismen. Dat is ongeveer net zoveel als het aantal cellen waaruit ons lichaam bestaat. Maar omdat bacteriën veel kleiner zijn, maken ze slechts twee kilogram van ons gewicht uit.
Uniek microbioom
Voor de 21ste eeuw was het grootste deel van wat over het menselijke microbioom bekend was afkomstig van enkele soorten die onderzoekers in een petrischaaltje konden kweken. Rond het jaar 2000 maakten ze een grote stap voorwaarts door DNA te isoleren uit spuug-, huid- en poepmonsters. Met die genetische informatie stelden wetenschappers een catalogus samen van de bacteriesoorten die in ons lichaam leven.
De lijst werd almaar langer en veel soorten waren nieuw voor microbiologen. Wat het nog verwarrender maakte, was dat de meeste soorten bij sommige mensen wel en bij andere niet voorkomen: het microbioom bleek nog unieker dan iemands vingerafdruk. Dus welke micro-organismen dominant zijn en hoe ze met elkaar samenwerken, kan bij de ene persoon compleet anders zijn dan bij de andere.
Stabiel ecosysteem
Volgens het Stanford-team was er maar een manier om dit verder uit te pluizen: zelf een microbioom creëren door afzonderlijke bacteriën in het lab te kweken en die vervolgens ‘mixen’. Eerst stelden de onderzoekers een lijst op van 166 soorten die bij een aanzienlijk deel van de mensen in de darmen zijn aangetroffen. Toen ze laboratoria en bedrijven benaderden, slaagden ze erin 104 bacteriesoorten in handen te krijgen.
Van deze soorten maakten de onderzoekers hun eerste microbioom: hCom1. Deze mix van bacteriën werd bij zogenoemde kiemvrije muizen, muizen die steriel geboren worden en hun hele leven in een steriele omgeving blijven, ingebracht. Na een tijdje werd de muizenpoep verzameld en bestudeerd, en wat bleek? De 104 soorten hadden een stabiel ecosysteem gecreëerd in de muizendarmpjes.
E. coli afgeweerd
Vervolgens stelden de wetenschappers hCom1 op de proef: ze transplanteerden poep van menselijke vrijwilligers in de muizen om te zien of het synthetische microbioom veerkrachtig genoeg was om die aanval te weerstaan. Dat bleek inderdaad zo te zijn. Slechts zeven bacteriesoorten verdwenen, maar door de poeptransplantatie kwamen er ook nieuwe bij.
Dat resulteerde in hCom2: een microbioom bestaande uit 119 unieke bacteriesoorten. Muizen met deze cocktail van micro-organismen waren nog gezonder. Zo overleefden ze een E. coli-aanval. Verder produceerden de dieren gezonde niveaus van spijsverteringssappen en ontwikkelden ze een volwaardig immuunsysteem.
Hoewel het nagemaakte microbioom nog verre van compleet is – er zijn zo’n 1100 verschillende soorten in het menselijke darmkanaal te vinden – is het een indrukwekkende prestatie. Bovendien levert het veel nieuwe kennis op. Zo is het Stanford-team al begonnen met experimenten waarbij het bepaalde microben uit de cocktail weglaat om beter te begrijpen hoe het microbioom werkt.
De onderzoekers stellen het bioom ter beschikking aan andere onderzoekers die hun eigen experimenten ermee willen uitvoeren.
Bronnen: Cell, Stanford University, The New York Times
Beeld: 123RF